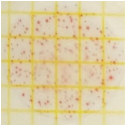
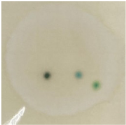

Hot Air-Assisted Radio Frequency (HARF) Drying on Wild Bitter Gourd Extract
Abstract
1. Introduction
2. Materials and Methods
2.1. Materials
2.2. Equipment
2.3. Focused Ultrasonic Extraction (FAE) and Hot Water Extraction (HWE) of Wild Bitter Gourd
2.4. Hot Air-Assisted Radio Frequency (HARF) Drying Extract from Wild Bitter Gourd
2.5. Analytical Methods
2.5.1. Protein Content Measurement
2.5.2. Total Saponins Measurement
2.5.3. DPPH Free Radical Scavenging Ability Test
2.5.4. Microbiological Test
2.6. Hypoglycemic Effect of Wild Bitter Gourd Extract on STZ-Induced Mice
2.6.1. Experimental Animal and Raising Environment
2.6.2. Preparation of Feed 5% Bitter Gourd Extract Powder
2.6.3. Regulated Blood Glucose Function Evaluation Method
2.7. Statistical Analysis
3. Results and Discussion
3.1. Focused Ultrasonic Extraction (FUE) of Wild Bitter Gourd
3.2. Hot Air-Assisted Radio Frequency (HARF) Drying of Extract from Wild Bitter Gourds
3.3. HARF Pasteurizing of Wild Bitter Gourd Extract
3.4. Hypoglycemic Effect of Radio Frequency Dried Wild Bitter Gourd Extract
4. Conclusions
Author Contributions
Funding
Institutional Review Board Statement
Informed Consent Statement
Data Availability Statement
Acknowledgments
Conflicts of Interest
References
- Oishi, Y.; Sakamoto, T.; Udagawa, H. Inhibition of increases in blood glucose and serum neutral fat by Momordica charantia saponin fraction. Biosci. Biotechnol. Biochem. 2007, 71, 735–740. [Google Scholar] [CrossRef] [PubMed]
- Zhu, Y.; Dong, Y.; Qian, X. Effect of superfine grinding on antidiabetic activity of bitter melon powder. Int. J. Mol. Sci. 2012, 13, 14203–14218. [Google Scholar] [CrossRef] [PubMed]
- Wang, Q.; Wu, X.; Shi, F.; Liu, Y. Comparison of antidiabetic effects of saponins and polysaccharides from Momordica charantia L. in STZ-induced type 2 diabetic mice. Biomed. Pharmacother. 2019, 109, 744–750. [Google Scholar] [CrossRef] [PubMed]
- Lo, H.; Ho, T.; Lin, C. Momordica charantia and its novel polypeptide regulate glucose homeostasis in mice via binding to insulin receptor. J. Agric. Food Chem. 2013, 63, 2461–2468. [Google Scholar] [CrossRef] [PubMed]
- Ahmad, Z.; Zamhuri, K.F.; Yaacob, A. In vitro anti-diabetic activities and chemical analysis of polyepetide-k and oil isolated from seeds of Momordica charantia (bitter gourd). Molecules 2012, 17, 9631–9640. [Google Scholar] [CrossRef]
- Cai, Z.; Qu, Z.; Lan, Y.; Zhao, S.; Ma, X.; Wan, Q.; Jing, P.; Li, P. Conventional, ultrasound-assisted, and accelerated-solvent extractions of anthocyanins from purple sweet potatoes. Food Chem. 2016, 197, 266–272. [Google Scholar] [CrossRef]
- Gil-Chávez, G.J.; Villa, J.A.; Fernando Ayala-Zavala, J.; Basilio Heredia, J.; Sepulveda, D.; Yahia, E.M.; González-Aguilar, G.A. Technologies for extraction and production of bioactive compounds to be used as nutraceuticals and food ingredients: An overview. Compr. Rev. Food Sci. Food Saf. 2013, 12, 5–23. [Google Scholar] [CrossRef]
- Caldas, T.W.; Mazza, K.E.; Teles, A.S.; Mattos, G.N.; Brígida, A.I.S.; Conte-Junior, C.A.; Borguini, R.G.; Godoy, R.L.; Cabral, L.M.; Tonon, R.V. Phenolic compounds recovery from grape skin using conventional and non-conventional extraction methods. Ind. Crops Prod. 2018, 111, 86–91. [Google Scholar] [CrossRef]
- Garude, H.S.; Ade, V.R.; Gadhave, R.K. Comparative study of various methods for extraction of antioxidants compound from bitter gourd peel. Adv. Life Sci. 2016, 5, 11189–11192. [Google Scholar]
- Tan, S.P.; Kha, T.C.; Parks, S.; Stathopoulos, C.; Roach, P.D. Optimising the encapsulation of an aqueous bitter melon extract by spray-drying. Foods 2015, 4, 400–419. [Google Scholar] [CrossRef]
- Tan, S.P.; Tuyen, C.K.; Parks, S.E.; Stathopoulos, C.E.; Roach, P.D. Effects of the spray-drying temperatures on the physiochemical properties of an encapsulated bitter melon aqueous extract powder. Powder Technol. 2015, 281, 65–75. [Google Scholar] [CrossRef]
- Raj, N.; Priya, B. Encapsulation of bitter gourd (Momordica charantia L.) extract by spray drying technique. Biosci. Biotechnol. Res. Asia 2016, 13, 1189–1193. [Google Scholar] [CrossRef][Green Version]
- Antigo, J.L.D.; Bergamasco, R.D.C.; Madrona, G.S. Effect of pH on the stability of red beet extract (Beta vulgaris L.) microcapsules produced by spray drying or freeze drying. Food Sci. Technol. 2018, 38, 72–77. [Google Scholar] [CrossRef]
- Zhou, X.; Wang, S. Recent developments in radio frequency drying of food and agricultural products: A review. Dry. Technol. 2019, 37, 271–286. [Google Scholar] [CrossRef]
- Marra, F.; Zhang, L.; Lyng, J.G. Radio frequency treatment of food: Review of recent advances. J. Food Eng. 2009, 91, 497–508. [Google Scholar] [CrossRef]
- Zhou, X.; Ramaswamy, H.; Qu, Y.; Xu, R.; Wang, S. Combined radio frequency-vacuum and hot air drying of kiwifruits: Effect on drying uniformity, energy efficiency and product quality. Innov. Food Sci. Emerg. Technol. 2019, 56, 102182. [Google Scholar] [CrossRef]
- Zhang, L.; Lan, R.; Zhang, B.; Erdogdu, F.; Wang, S. A comprehensive review on recent developments of radio frequency treatment for pasteurizing agricultural products. Crit. Rev. Food Sci. Nutr. 2021, 61, 380–394. [Google Scholar] [CrossRef]
- Zhu, H.; Li, D.; Ma, J.; Du, Z.; Li, P.; Li, S.; Wang, S. Radio frequency heating uniformity evaluation for mid-high moisture food treated with cylindrical electromagnetic wave conductors. Innov. Food Sci. Emerg. Technol. 2018, 47, 56–70. [Google Scholar] [CrossRef]
- Gong, C.; Liao, M.; Zhang, H.; Xu, Y.; Miao, Y.; Jiao, S. Investigation of hot air–assisted radio frequency as a final-stage drying of pre-dried carrot cubes. Food Bioproc. Technol. 2020, 13, 419–429. [Google Scholar] [CrossRef]
- Li, J.; Huang, Y.; Liu, N.; Chen, S.; Liu, X. Study on stability of momordicosides. Food Sci. 2008, 10, 109–111. (In Chinese) [Google Scholar]
- Xu, B.J.; Chang, S.K.C. A comparative study on phenolic profiles and antioxidant activities of legumes as affected by extraction solvents. J. Food Sci. 2007, 72, 159–166. [Google Scholar] [CrossRef] [PubMed]
- Yan, J.K.; Yu, Y.B.; Wang, C.; Cai, W.D.; Wu, L.X.; Yang, Y.; Zhang, H.N. Production, physicochemical characteristics, and in vitro biological activities of polysaccharides obtained from fresh bitter gourd (Momordica charantia L.) via room temperature extraction techniques. Food Chem. 2021, 337, 127798. [Google Scholar] [CrossRef] [PubMed]
- Xu, X.; Shan, B.; Liao, C.H.; Xie, J.H.; Wen, P.W.; Shi, J.Y. Anti-diabetic properties of Momordica charantia L. polysaccharide in alloxan-induced diabetic mice. Int. J. Biol. Macromol. 2015, 81, 538–543. [Google Scholar] [CrossRef] [PubMed]


| Extraction Method | FUE | HWE |
|---|---|---|
| Extraction temperature (°C) | 70 | 100 |
| Extraction time (min) | 10 | 60 |
| Extraction yield (%) | 22.4 ± 0.1 * | 21.0 ± 0.0 |
| Total saponins (mg/g) | 0.288 ± 0.002 | 0.296 ± 0.022 * |
| Total proteins (mg/g) | 1.198 ± 0.025 | 1.302 ± 0.032 * |
| Scavenging DPPH ability (%) | 79.2 ± 0.1 * | 59.6 ± 0.1 |
| E:F | Loading (kg) | Linear Regression Equation | R2 | Rate (g/min) |
|---|---|---|---|---|
| 2:1 | 1.0 | W = −36.881t + 1007.8 | 0.996 | 36.881 |
| 2:1.1 | 1.0 | W = −43.836t + 1066.4 | 0.984 | 43.836 |
| 2:1.2 | 1.0 | W = −53.968t + 1103.2 | 0.995 | 53.968 |
| Wild Bitter Gourd Sample | Extract from Wild Bitter Gourd | Soybean Fiber Powder | RF-Dried Extract Fiber Product |
|---|---|---|---|
| Total bacterial colonies | |||
| CFU/mL | 523,000 | 9400 | 30 |
| Picture (1:10) | ![]() | ![]() | ![]() |
| Mold and yeast counts | |||
| CFU/mL | >1000 | 30 | <10 |
| Picture (1:10) | ![]() | ![]() | ![]() |
| Group | 0 Week | 1 Week | 2 Weeks | 3 Weeks | 4 Weeks |
|---|---|---|---|---|---|
| Normal | 23.05 ± 1.64 b | 23.69 ± 1.65 a | 24.03 ± 1.63 a | 24.61 ± 1.21 a | 24.95 ± 1.57 a |
| STZ | 22.58 ± 0.88 ab | 22.94 ± 1.27 a | 23.67 ± 1.38 a | 24.01 ± 1.45 a | 24.78 ± 1.32 a |
| STZ + Extract | 21.69 ± 0.93 a | 23.66 ± 2.09 a | 24.16 ± 2.49 a | 24.90 ± 2.30 a | 25.35 ± 2.06a |
| Group | 0 Week | 4 Weeks |
|---|---|---|
| Normal | 74.88 ± 6.20 b | 90.00 ± 6.50 c |
| STZ | 107.00 ± 6.21 a | 115.13 ± 5.69 a |
| STZ + Extract | 105.63 ± 4.34 a | 105.38 ± 4.07 b |
Publisher’s Note: MDPI stays neutral with regard to jurisdictional claims in published maps and institutional affiliations. |
© 2022 by the authors. Licensee MDPI, Basel, Switzerland. This article is an open access article distributed under the terms and conditions of the Creative Commons Attribution (CC BY) license (https://creativecommons.org/licenses/by/4.0/).
Share and Cite
Huang, C.-Y.; Cheng, Y.-H.; Chen, S.-D. Hot Air-Assisted Radio Frequency (HARF) Drying on Wild Bitter Gourd Extract. Foods 2022, 11, 1173. https://doi.org/10.3390/foods11081173
Huang C-Y, Cheng Y-H, Chen S-D. Hot Air-Assisted Radio Frequency (HARF) Drying on Wild Bitter Gourd Extract. Foods. 2022; 11(8):1173. https://doi.org/10.3390/foods11081173
Chicago/Turabian StyleHuang, Chang-Yi, Yu-Huang Cheng, and Su-Der Chen. 2022. "Hot Air-Assisted Radio Frequency (HARF) Drying on Wild Bitter Gourd Extract" Foods 11, no. 8: 1173. https://doi.org/10.3390/foods11081173
APA StyleHuang, C.-Y., Cheng, Y.-H., & Chen, S.-D. (2022). Hot Air-Assisted Radio Frequency (HARF) Drying on Wild Bitter Gourd Extract. Foods, 11(8), 1173. https://doi.org/10.3390/foods11081173